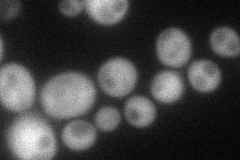
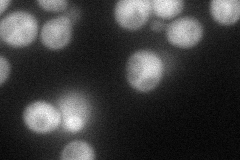
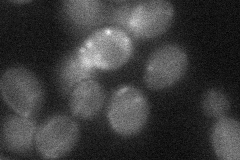
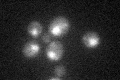

View description
Forkhead family transcription factor with a major role in the expression of G2/M phase genes; positively regulates transcriptional elongation; negative role in chromatin silencing at HML and HMR; substrate of the Cdc28p/Clb5p kinase
Localization:
Intensity:
Fold change:
Significance:
-
C’ GFP library in SD

nucleus24.45 -
N' NOP1pr-GFP in SD
cytosol55.3088 -
N' TEF2pr-mCherry in SD
cytosol61.9399 -
N' NATIVEpr-GFP in SD

below threshold21.2257 -
N' TEF2pr-VC and Cyto-VN in SD
below threshold27.0489 -
C’ GFP library in SD+DTT

nucleus22.20.9No -
C’ GFP library in SD+H2O2
nucleus26.151.06No -
C’ GFP library in Starvation Media

nucleus23.080.94No -
C’ GFP library on the background of Pup2-DaMP

nucleus -
C’ GFP library on the background of CCT mutant

nucleus25.58071.04597No
